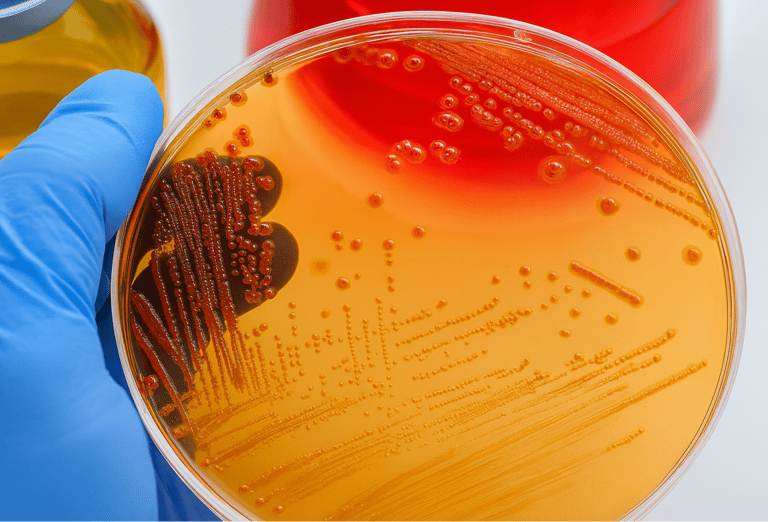
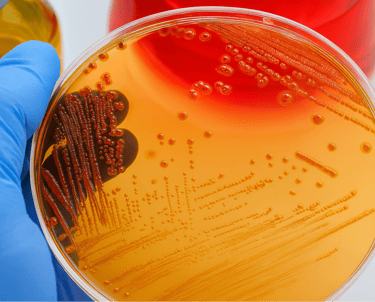

Biologisation of chemistry
The global production of chemicals from renewable raw materials exceeded USD 86 billion in 2020.
Experts predict that by 2025, chemicals from renewable sources will account for 15–20% of global chemical production.
Industrial biotechnology products include high-volume basic chemicals:
Organic acids and their derivatives
Alcohols
Alkenes
Glycols
Biocatalysts and industrial enzymes
Reagents for pulp and paper production
and many others


The three main types of vegetation—algae, forests, and agricultural crops—produce around 2,000 billion tons of dry organic matter annually. In comparison, the extraction of fossil organic materials amounts to about 2 billion tons per year,
which is roughly 1% of the biomass synthesized each year.


Fermentation already allows the use of microorganisms as biofactories for producing almost any complex organic molecules:
All types of proteins
Amino acids and organic acids
Enzymes
Vitamins, vaccines and antibiotics
Bioplastics
Microbiological fertilisers
Bioproducts for wastewater treatment
- all at high speed, large scale and low cost


In November 2020, the World Economic Forum named fermentation a key area of global innovation
Today, biopolymers make up less than 1% of the global plastics market. However, expert estimates suggest that by 2030, biopolymer production from plant biomass will exceed 30 million tons annually.
Industrial-scale production has already been achieved for biopolymers based on starch, polylactic acid (PLA), alkyd resins, and cellulose with 100% bio-based content.
Current efforts focus on making traditional industrial polymers—such as polyethylene, polypropylene, polystyrene, and polyethylene terephthalate—biodegradable.


Nutrient media must contain all essential substances in an easily absorbable form—primarily sources of nitrogen and carbon—to meet the nutritional and energy needs of microorganisms.
Growth factors such as vitamins and certain amino acids that the cell cannot synthesize are often added to the media.
Products of deep processing of grain + other plant and animal resources:
Glucose
Maltose
Fructose and other monosaccharides
Amino acids
Hydrolysates of plant and animal proteins
- are key ingredients in nutrient media for cultivating microorganisms

Get in touch


